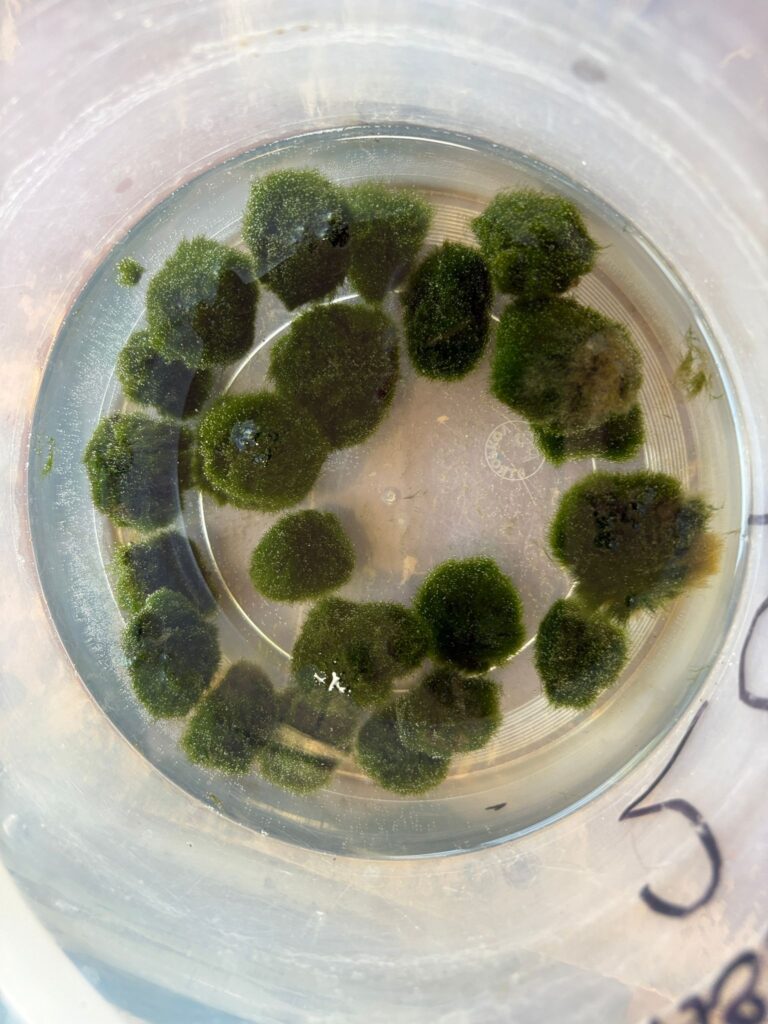

V sobotu, 26. dubna 2025, se ve Středisku volného času v Mostě konaly již tradičně pod hlavičkou spolku Akvatera, Akvarijní trhy. Byly zde k vidění a zakoupení nejen akvarijní rybičky, ale také vybavení do akvárií, krmivo, i pár opravdových kuriozit.
První patro budovy se z prostoru pro dětské zájmové kroužky proměnilo ve vodní svět. Celá akce začala v 9 hodin ráno, fronta před střediskem se však tvořila již zhruba čtvrt hodiny před zahájením.
Návštěvníci – milovníci akvaristiky a sladkovodních rybiček – měli opravdu z čeho vybírat. Na místě byly k vidění a prodeji desítky, ne-li stovky druhů. Rybičky barevné, žíhané, zářivé, zkrátka vše a ještě mnohem více. K zakoupení bylo také mnoho akvárií, jakož i vybavení do nich: teploměry, osvětlení či filtry. Z dekorací to byly potom živé či umělé rostliny, kameny, písek či domečky např. pro ráčky, kteří se tu a tam mezi rybkami také objevili. Dále jsme spatřili speciální druh krmiva – lízátka pro krevetky.
Kromě chovatelů rybiček si našly své i děti. V jednom ze stánků byly k prodeji klíčenky s motivem různých druhů barevných ryb.
Akvarijní trhy trvaly až do 12. hodiny, noví návštěvníci přicházeli po celou dobu. To dokazuje, že milovníků tohoto oboru je na Mostecku opravdu spousta.

Foto, video a text: Miroslav Ludvík


